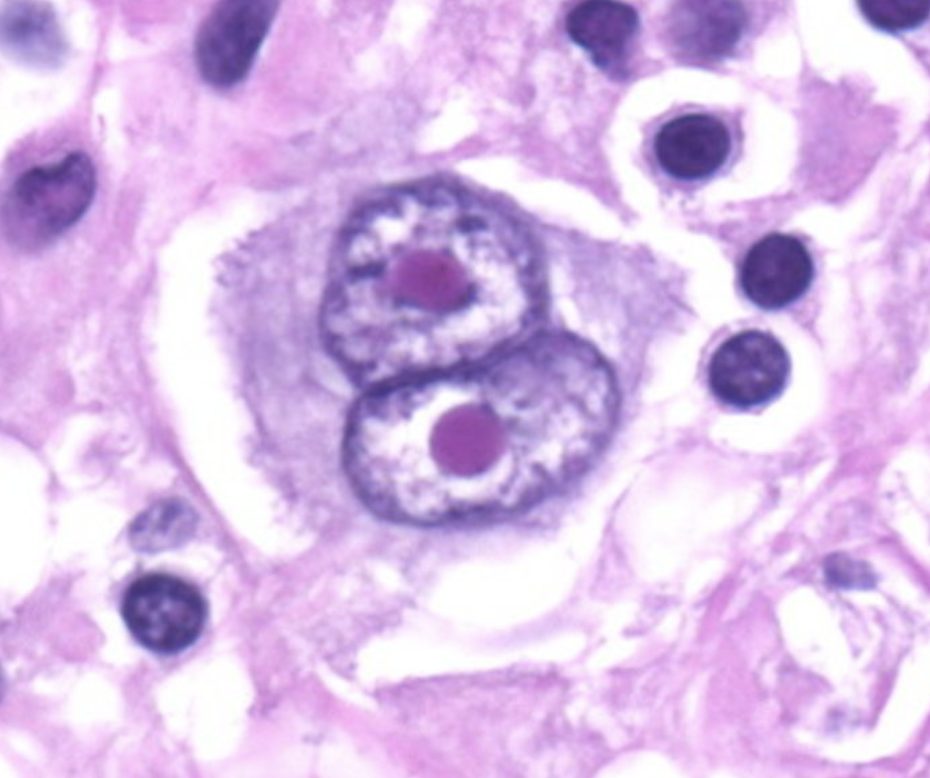
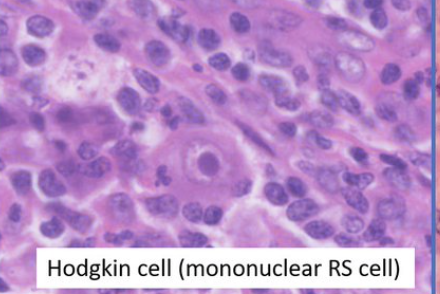
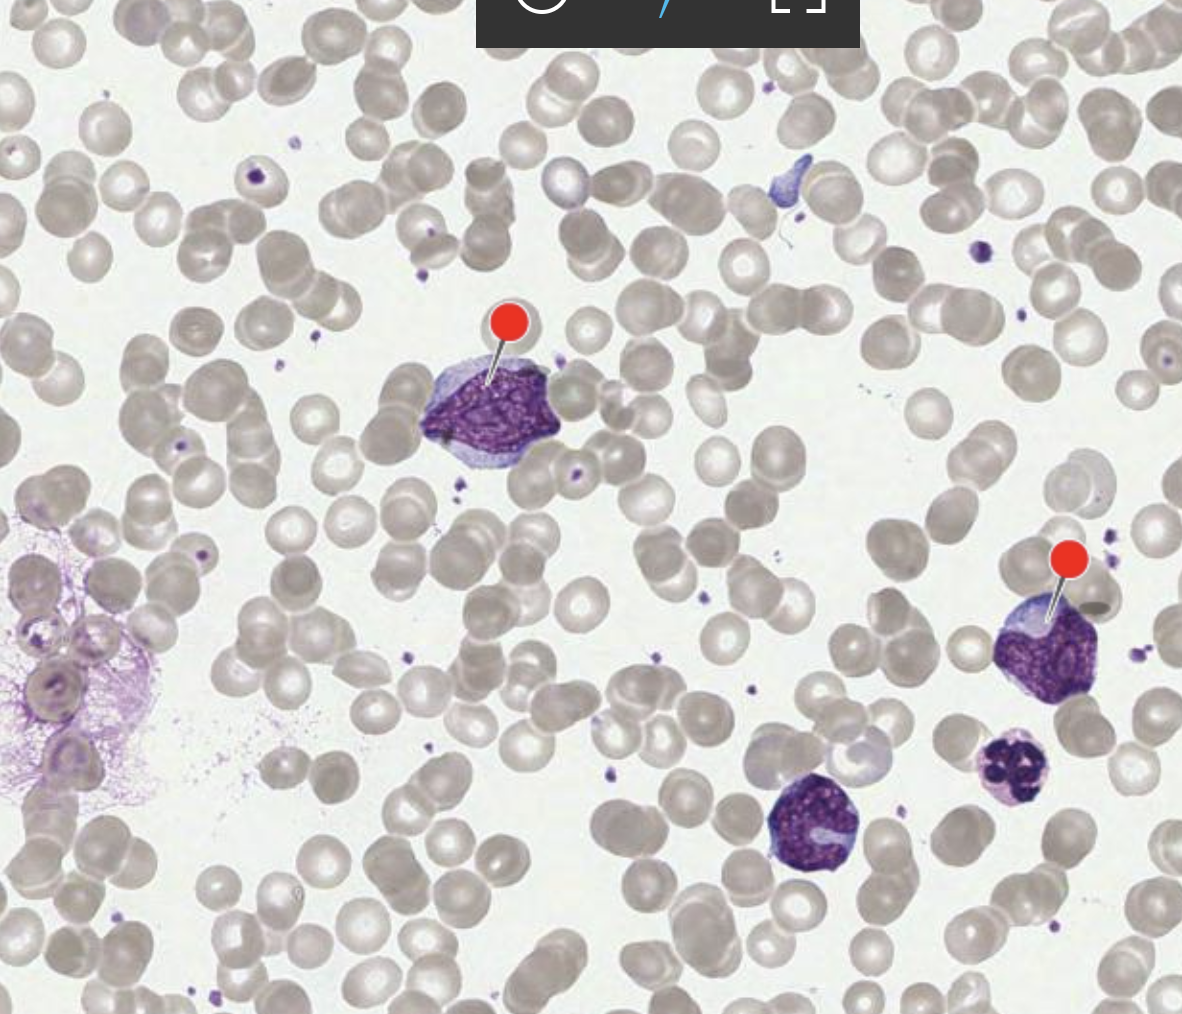
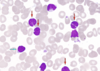

What is a lymphoma?
What are common sites of presentation of lymphomas
Lymphoma = neoplasm of lymphoid cells
Usually found in
1. Lymphatic system (lymph nodes, BM or blood)
2. Lymhpoid organy: Spleen or gut associated lymphoid tissue
3. Skin (often T-cell lymphomas)
- Rarely: anywher else in the body

What is the incidence of lymphomas in the UK?
Are hodgkin or non-hodgkin’s lymphomas more common?
Around 200/1.000.000 new diagnosis per year
Non-Hodgkin’s 80%
Hodgekins 20%
What is usually the first step of classifying Lymphomas?
Classification into
1. Hodgkin lymphoma (20%)
2. Non-Hodgkin lymphomas (80%)

What are the characterisics of Hodgekin Lymphomas?
Historical + histological difference to NHL
Malignant Lymphoma usually of B-cell origin, with the presence of Reed-Sternbeg cells (picture below) or the presence of Hodgekin cells
Clinical: single/ localised in one group of lymph nodes

What is the epidemiology of Hodgekin Lymphmas?
Bimodal age disribution
1st peak: 25-30 years
2nd peak: 50-70 years (EBV association)
In paediatrics: male dominance

How is Hodgekin’s lymphoma sub-classified?
Classified into
1. Classical HL (95%) –> focus of future flashcards
2. nodular lymphocyte predominant HL (5%) (similar presentation to B cell -NHL)
A paient presents with the following cell on lymph node biopsy: What is the diagnosis?
Cell: Reed- Sternberg cell –> Large binucleaed or polylobaed cells with large nucleoli (malignant B-cells)
–> owel eye appearance
Pathonognomic for Hodgekin lymphomas
What is a Hodgkin cell? What is its significance in the diagnosis of Hodgekin lymphomas?
Large mononuclear cells with large nucleoli of B-cell origin
Can be present in HL, but pathonognomic cell for diagnoss and more commonly present is Reed-sernber cell
What are risk factors associaed with the devleopment of Hodgekin Lymphomas?
- Strong association with Epstein-Barr virus (EBV)
- Immunodeficiency: HIV, transplant, immunosuppression
- Autoimmune diseases (e.g., rheumatoid arthritis, sarcoidosis)
What is the clinical presentation of Hodgekin lymphoma?
- B-symptoms
- Painless lymphadenopathy (if in mediastinum: might only be cough) –> usually single-group of lymph nodes above the mediastinum
- Pruritus
- Lymph node pain associated with alcohol (rare but v.specific)
How is Hodgekin lymphoma diagnosed (what investigations + respective findings) ?
Mainly history + Lymph node biopsy
1. Bloods
FBC: can be normal, high or low WCC, anaemia, eosinophilia
LDH: increased
calcium: can be increased if paraneoplastic syndrome
- Biopsy
Reed-Sternberg cells (don’t express normal B-cell markers (CD20 and 45 but do expressed CD 15)
Potential inflammation + granuloma formation - Imaging: disease spread (CT/ PET)
How is Hodgekin Lymphoma staged?
Staged by using Ann Arbor system with reference to the diaphragm
+ A for no constitutional symptoms
+ B for constitutional symptoms

What is the prognosis of Hodgekin Lymphoma?
Generally good (80-90% 5 year survival), especially in young
–> Curative approach of treatment, regardless of stage
What is the approach to treatment of Hodgekin Lymphoma?
Stage 1+2: Combination Chemo + Radiotherapy (very high risk of breast cancer in female)
Stage 3-4: Chemotherapy with radiotherapy in selected cases
If fails or in remission: Stem-cell transplnat (usually autologous)
What is a typical chemotherapy regime used in the treatment of Hodgekin’s lymphoma?
ABVD
Adriamycin
Bleomycin
Vinblastine
Dacarbazine
What are the 2 main categories in which non-Hodgekin Lymphomas are sub-classified?
Which one is more common?
Non-Hodgekin Lymphomas then classfied into
1. B-cell 85% and
2. T-cell
3. (NK cells very rare)

What is the epidemiology of non-Hodgekin lymphomas?
NHL is the most common Haematopoetic neoplasm
Male> Female
- Incidence increases with age, peak incidence >50 years
- High-grade are more common in children and young adults (20-40)
What is the overall clinical presenation of non- Hodgekin lymphomas?
Depending on subtype, but overall
High grade:
1. Localised or genralised lymphadenopathy
2. B-symptoms (but more common in HL than NHL)
2. Hepato or Splenomegaly
3. Abdominal discomfort, anaemia, fatigue, change in mental status
Low grade
* Often asymptomatic, insidious onset
How are non-Hodgekin lymphomas staged?
Same staging as HL: Ann Arbor + A and B
+ A for no constitutional symptoms
+ B for constitutional symptoms

What Bloods results might indicate a Lymphoma and which ones should you do?
Depening on stage, aggressiveness etc and can be normal
- FBC (anaemia, cytopenia (infiltration or chronic disease)
- High ESR
- If B-cell –> rouleaux formation (if paraprotein present)
- Cold agglutinin
Others needed
1. U&E, LFTs, LDH
2. Serum protein electrophoresis
3. BBV screen (HIV, Hep B and C)
You have esablished that a patient has a
1. Non- Hodgekin Lymphoma of
2. B-cell origin
How can it be further sub-classified?
By maturity of cells
1. Mature
2. Immature (much closer to ALL)
If mature: by aggressiveness of disease
1. Aggressiveness
2. Indolent
3. Other

What is the most common B-cell NHL?
What is the malignant cells that are present in it?
Diffuse large B-cell lymphoma
(40% of all NHL)
–> Mature Large B-cells

What is the epidemiology and prognosis of Diffuse Large B-cell lymphomas?
Can occur any age, most common middle aged and elderly
Usually agressive, but 60% can be cured after 6 months of aggressive chemo
Can occur from malignant transformation of low-grade lymphomas
What are the histological findings of Large B-cell lymphomas?
Sheets of large lymphoid cells